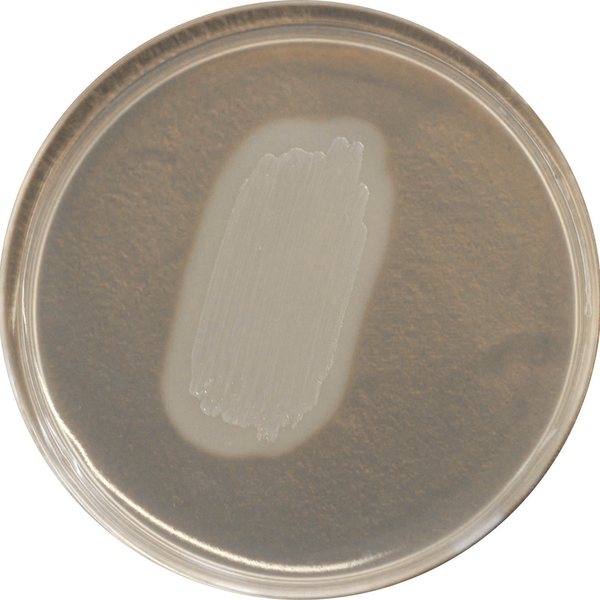
CHROMagar™ Identification Listeria

Hình thái khuẩn lạc

L. monocytogenes
Hồng với quầng trắng

L. ivanovii
Không màu với quầng trắng

L. innocua
Hồng không có quầng
Hiệu năng
Hiệu năng
Listeria monocytogenes là một loài vi khuẩn phổ biến, có mặt trong đất, nước thải hoặc chất thải. Khả năng tạo biofilm listerial trên bề mặt tiếp xúc khiến cho việc loại bỏ trở nên khó khăn. Tác nhân gây bệnh này có thể gây ngộ độc thực phẩm nghiêm trọng và do đó thường xuyên là mục tiêu kiểm soát chất lượng vi sinh trong các cơ sở chế biến thực phẩm để tránh ô nhiễm thực phẩm. Ô nhiễm có thể xảy ra ở tất cả các bước trong chuỗi sản xuất thực phẩm từ nguyên liệu thô đến nơi tiêu thụ.
CHROMagar™ đã phát triển một phương pháp nhanh chóng để phát hiện L. monocytogenes trong thực phẩm, bao gồm các bước đơn giản sau (1) làm giàu trong nước lèo half frazer trong 24h, (2) phân lập trong CHROMagar™ Listeria, (3) xác nhận loài Listeria monocytogenes trong CHROMagar™ Identification Listeria.

1. Đơn giản và cho kết quả nhanh chóng: Các thử nghiệm xác nhận cổ điển cho loài L. monocytogenes bao gồm nhiều bước phức tạp và tốn thời gian.
CHROMagar™ Identification Listeria đơn giản hóa bước xác nhận loài và giảm tải công việc, do đó cải thiện hiệu quả của phòng thí nghiệm.
Một đốm khuẩn lạc nghi ngờ lấy từ CHROMagar™ Listeria được đặt trực tiếp lên CHROMagar™ Identification Listeria sẽ cung cấp xác nhận loài L. monocytogenes trong vòng 24 giờ.
Thành phần

Xem thêm